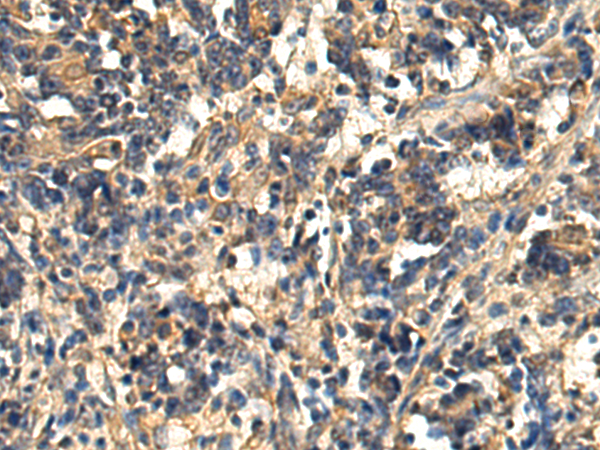

中文名稱 : 小鼠抗MAPK1/MAPK3單克隆抗體
|
Background: |
The protein encoded by this gene is a member of the MAP kinase family. MAP kinases, also known as extracellular signal-regulated kinases (ERKs), act in a signaling cascade that regulates various cellular processes such as proliferation, differentiation, and cell cycle progression in response to a variety of extracellular signals. This kinase is activated by upstream kinases, resulting in its translocation to the nucleus where it phosphorylates nuclear targets. Alternatively spliced transcript variants encoding different protein isoforms have been described. |
|
Applications: |
WB, IHC |
|
Name of antibody: |
MAPK1/MAPK3 |
|
Immunogen: |
Fusion protein of human MAPK1/MAPK3 |
|
Full name: |
mitogen-activated protein kinase 1/3 |
|
Synonyms: |
ERK1, ERK2, ERK1/2 |
|
SwissProt: |
P28482/P27361 |
|
IHC positive control: |
Human liver cancer and Human gastric cancer; Human thyroid cancer and Human esophagus cancer |
|
IHC Recommend dilution: |
100-500 |
|
WB Predicted band size: |
41/43 kDa |
|
WB Positive control: |
Human thyroid tissue, Human cerebella tissue, NIH/3T3 cell, 231 cell, Hela cell lysates |
|
WB Recommended dilution: |
1000-5000 |

購物車
幫助
021-54845833/15800441009
